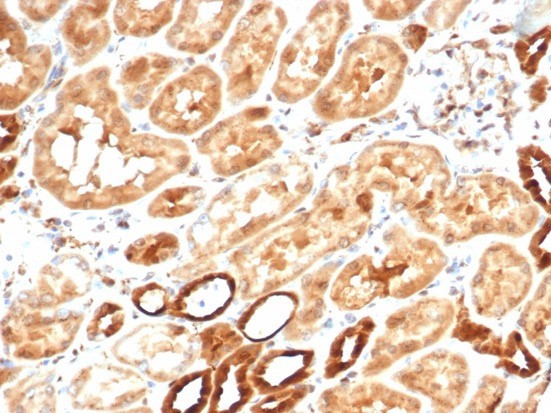
Aldo-keto Reductase Family 1 Member B1 (Adrenal Marker) Antibody in Immunohistochemistry (Paraffin) (IHC (P))

Search
NeoBiotechnologies
Aldo-keto Reductase Family 1 Member B1 (Adrenal Marker) Recombinant Rabbit Monoclonal Antibody (AKR1B1/7010R)
{{$productOrderCtrl.translations['antibody.pdp.commerceCard.promotion.promotions']}}
{{$productOrderCtrl.translations['antibody.pdp.commerceCard.promotion.viewpromo']}}
{{$productOrderCtrl.translations['antibody.pdp.commerceCard.promotion.promocode']}}: {{promo.promoCode}} {{promo.promoTitle}} {{promo.promoDescription}}. {{$productOrderCtrl.translations['antibody.pdp.commerceCard.promotion.learnmore']}}
图: 1 / 3
Aldo-keto Reductase Family 1 Member B1 (Adrenal Marker) Antibody (231-RBM4-P1ABX) in IHC (P)



产品信息
231-RBM4-P1ABX
种属反应
宿主/亚型
Expression System
分类
类型
克隆号
抗原
偶联物
形式
浓度
规格
纯化类型
保存液
内含物
保存条件
运输条件
靶标信息
Catalyzes the NADPH-dependent reduction of a wide variety of carbonyl-containing compounds to their corresponding alcohols with a broad range of catalytic efficiencies.
仅用于科研。不用于诊断过程。未经明确授权不得转售。
篇参考文献 (0)
生物信息学
蛋白别名: AKR1B1; Aldehyde reductase; aldehyde reductase 1; aldo-keto reductase family 1; Aldo-keto reductase family 1 member B1; Aldose reductase; aldose reductase (EC 1.1.1.21); AR; Lii5-2 CTCL tumor antigen; low Km aldose reductase; member B1 (aldose reductase); unnamed protein product
基因别名: ADR; AKR1B1; ALDR1; ALR2; AR
UniProt ID: (Human) P15121
Entrez Gene ID: (Human) 231